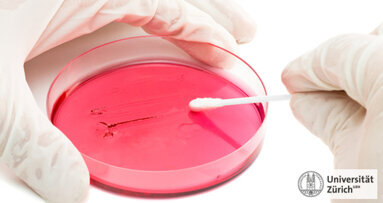
Versteckte Bakterien aufspüren

ZÜRICH/LEIPZIG – Wird ein Implantat gesetzt, kommt es bei jedem zehnten Patienten zu Komplikationen wie etwa Periimplantitis. Züricher Wissenschaftler haben ein Verfahren entwickelt, in dem mit Hilfe von Strom Bakterien abgetötet werden, die am Implantat Infektionen verursachen können.
Wer sich in die Hände seines Zahnarztes begibt, rechnet nicht damit, dass er von ihm unter Strom gesetzt wird. Das könnte in Zukunft jedoch tatsächlich der Fall sein. Was sich erst einmal gefährlich anhört, ist laut Experten eine schmerzfreie und medizinisch durchaus sinnvolle Prozedur, um Infektionen an Zahnimplantaten zu verhindern. Eine neue Laborstudie hat gezeigt, dass eine 15-minütige Stromzufuhr von weniger als 10 Milliampere einen Großteil der Bakterien am Implantat abtöten kann.
embedImagecenter("Imagecenter_1_255",255, "large");
Wissenschaftler der Eidgenössischen Technischen Hochschule (ETH) Zürich und dem Zentrum für Zahnmedizin der Universität Zürich haben in Versuchen ein nicht-invasives Verfahren entwickelt, um Entzündungen am Implantat effizient und schonend zu behandeln. Die Versuche waren ein Teil der Doktorarbeit von Dirk Mohn vom ETH-Institut für Chemie- und Bioingenieurwissenschaften. „Die Idee kam ursprünglich von Prof. Dr. Thomas Imfeld, Universität Zürich, der diese Idee zusammen mit meinem Doktorvater, Prof. Wendelin J. Stark, ETH Zürich, weiterentwickelte. Wir haben dieses Thema auch in Angriff genommen, um einem aktuellen Problem in der Zahnmedizin mit einem innovativen Lösungsansatz entgegenzutreten“, erklärte Mohn gegenüber Dental Tribune Online.
Probleme bei Implantaten
In den letzten zehn Jahren hat sich die Zahl der eingesetzten Zahnimplantate in Europa und den USA verdoppelt. Bei circa zehn Prozent der Implantate treten Probleme auf, meist im ersten Jahr nach dem Eingriff.
In ihren Versuchen orientierten sich die Forscher an einem Verfahren zur Wasserreinigung, bei dem mit Hilfe von Strom eine Elektrolyse, also das Zersetzen einer stromleitenden Flüssigkeit, erzeugt wird. „Die Wasserreinigung nimmt sich die Elektrolyse zur Hilfe, um sauberes Trinkwasser herzustellen. Aufgrund von Salz im Wasser entsteht bei der Elektrolyse Chlor, welches das Wasser anschliessend desinfiziert“, sagte Dirk Mohn.
In ihren Experimenten verwendeten die Wissenschaftler ein mit physiologischer Kochsalzlösung hergestelltes Gelatinepräparat, um die Situation im Kiefer zu simulieren. In dieses Präparat platzierten sie Titan-Implantate, die sie zuvor mit einem Bakterienfilm beschichteten. „In unseren Versuchen haben wir Escherichia coli-Bakterien benutzt, welche auch bei Periimplantitis-Patienten gefunden werden. Diese Darmbakterien bilden Biofilme und eignen sich gut für Laborversuche, da sie relativ einfach angezüchtet werden können“, erklärte Mohn. Die Keimmenge habe in etwa der entsprochen, die man im Mund erwarten kann.
Für die Tests diente ein Implantat als Kathode, also als Minuspol, und eines als Anode, Pluspol. Für 15 Minuten wurden die Implantate Stromstärken zwischen 0 und 10 Milliampere ausgesetzt. Aus der Kochsalzlösung entstanden im Laufe des Verfahrens stark oxidative, in dieser Konzentration jedoch ungefährliche Substanzen wie Chlor. Diese Substanzen haben eine sehr hohe desinfizierende Wirkung.
99 Prozent der Bakterien abgetötet
In den Versuchsreihen zeigte sich, dass bei den als Anode funktionierenden Implantaten nach einer Behandlung von 15 Minuten und einer Stromstärke von weniger als 10 Milliampere etwa 99 Prozent der
Bakterien abgetötet werden.
Derzeit erweitern die Wissenschaftler ihre In-vitro-Versuche mit einer breiteren Bakterienpopulation, die der Bakterienvielfalt im Mund entspricht. Die Ergebnisse der ersten Studie sind laut Dirk Mohn repräsentativ, auch wenn die verwendeten Bakterien nicht denen entsprechen, die im Mund für die Entzündungen verantwortlich sind. „Es wurde gezeigt, dass das Prinzip der Elektrolyse nicht nur für die Wasserreinigung genutzt werden kann. Diese Methode kann somit direkt und lokal Bakterien abtöten, welche einem Implantat anhaften.“
Laut der Forscher würde in Zukunft das Implantat von Patienten die Funktion der Anode übernehmen. Ein Clip an der Lippe könnte als Kathode verwendet werden. Derzeit entwickeln die Wissenschaftler ein entsprechendes Gerät, das zum Beispiel an Hunden getestet werden könnte.
Sollte das von den Forschern entwickelte Verfahren Einzug in die Zahnarztpraxen halten, brauchen Patienten sich nicht vor einer schmerzhaften Behandlung zu fürchten. Der Strom würde schlimmstenfalls leichte Muskelkontraktionen auslösen, erklärt Dirk Mohn. Vermutlich würde man ihn vor allem bei starken Änderungen, sprich Ein- und Ausschalten, spüren. „Falls nötig, kann einem Patienten aber auch eine lokale Anästhesie verabreicht werden“, so der Doktorierende.
Bei dieser Art der Desinfektion besteht allerdings, wie auch bei anderen Behandlungsmethoden ein Risiko. Laut Mohn tötet man mit dem Strom, bzw. den desinfizierenden Substanzen, eventuell nicht nur die Bakterien ab. Es könnte auch sein, dass Bindegewebs- und Knochenzellen in unmittelbarer Umgebung des Implantates geschädigt werden. Diese müssten durch den Heilungsprozess des Körpers ersetzt werden. Entsprechende Laborversuche zur Auswirkung auf Körperzellen sind geplant.
STUTTGART – Bakterien haften besonders gut durch die Ausscheidung von Polymeren, wie eine Untersuchung der Universität Stuttgart belegt.
Bern – Die Entdeckung der Antibiotika im 20. Jahrhundert bedeutete für die Medizin eine Revolution und hat unzähligen Menschen das Leben gerettet. Doch ...
Genf – Die Sektion Women Dentists Worldwide (WDW) der FDI World Dental Federation hat eine neue internationale Umfrage gestartet. Ziel ist es, aktuelle ...
ZÜRICH - Forscher der Eidgenössischen Technischen Hochschule (ETH) Zürich konnten zeigen, dass der Atem von Menschen einen charakteristischen...
LONDON – Karies heilt niemals selbst, sobald ein Loch entstanden ist. Wird die Oberfläche der Zahnhartsubstanz durchbrochen, muss die ...
HANNOVER - Unter der Federführung der Medizinischen Hochschule Hannover (MHH) werden Medizinerinnen und Mediziner der MHH gemeinsam mit Ingenieur- und ...
TOKIO - Subperiostale Implantate brauchten bisher relativ lang, bis eine Integration in den Knochen stattgefunden hat. Forscher aus Tokio haben nun ...
BERN – Forschende der Zahnmedizinischen Kliniken (ZMK) Bern haben in einer umfangreichen Langzeitstudie gezeigt, dass bei der Routinebehandlung mit ...
ZÜRICH - Die Bakterienkultur, die bisher als beste Methode für den Nachweis einer bakteriellen Infektion galt, versagt offenbar in vielen ...
YOKOSUKA, Japan – Dass es im Zusammenhang mit der Einnahme von Bisphosphonaten zu Komplikationen bei Implantaten kommen kann, ist bereits hinlänglich ...
Live-Webinar
Di. 23. Juni 2026
2:00 Uhr (CET) Zurich
Live-Webinar
Di. 23. Juni 2026
19:00 Uhr (CET) Zurich
Live-Webinar
Di. 23. Juni 2026
21:00 Uhr (CET) Zurich
Live-Webinar
Mi. 24. Juni 2026
14:00 Uhr (CET) Zurich
Live-Webinar
Mi. 24. Juni 2026
17:00 Uhr (CET) Zurich
Live-Webinar
Mi. 24. Juni 2026
18:30 Uhr (CET) Zurich
Dr. med. dent. Britta Hahn
Live-Webinar
Do. 25. Juni 2026
20:00 Uhr (CET) Zurich
Dr. Hatem Algraffee, Cat Edney



 Österreich / Österreich
Österreich / Österreich
 Bosnien und Herzegowina / Босна и Херцеговина
Bosnien und Herzegowina / Босна и Херцеговина
 Bulgarien / България
Bulgarien / България
 Kroatien / Hrvatska
Kroatien / Hrvatska
 Tschechien & Slowakei / Česká republika & Slovensko
Tschechien & Slowakei / Česká republika & Slovensko
 Frankreich / France
Frankreich / France
 Deutschland / Deutschland
Deutschland / Deutschland
 Griechenland / ΕΛΛΑΔΑ
Griechenland / ΕΛΛΑΔΑ
 Ungarn / Hungary
Ungarn / Hungary
 Italien / Italia
Italien / Italia
 Niederlande / Nederland
Niederlande / Nederland
 Nordic / Nordic
Nordic / Nordic
 Polen / Polska
Polen / Polska
 Portugal / Portugal
Portugal / Portugal
 Rumänien & Moldawien / România & Moldova
Rumänien & Moldawien / România & Moldova
 Slowenien / Slovenija
Slowenien / Slovenija
 Serbien & Montenegro / Србија и Црна Гора
Serbien & Montenegro / Србија и Црна Гора
 Spanien / España
Spanien / España
 Schweiz / Schweiz
Schweiz / Schweiz
 Türkei / Türkiye
Türkei / Türkiye
 Großbritannien und Irland / UK & Ireland
Großbritannien und Irland / UK & Ireland
 International / International
International / International
 Brasilien / Brasil
Brasilien / Brasil
 Kanada / Canada
Kanada / Canada
 Lateinamerika / Latinoamérica
Lateinamerika / Latinoamérica
 USA / USA
USA / USA
 China / 中国
China / 中国
 Indien / भारत गणराज्य
Indien / भारत गणराज्य
 Pakistan / Pākistān
Pakistan / Pākistān
 Vietnam / Việt Nam
Vietnam / Việt Nam
 ASEAN / ASEAN
ASEAN / ASEAN
 Israel / מְדִינַת יִשְׂרָאֵל
Israel / מְדִינַת יִשְׂרָאֵל
 Algerien, Marokko und Tunesien / الجزائر والمغرب وتونس
Algerien, Marokko und Tunesien / الجزائر والمغرب وتونس
 Naher Osten / Middle East
Naher Osten / Middle East

To post a reply please login or register